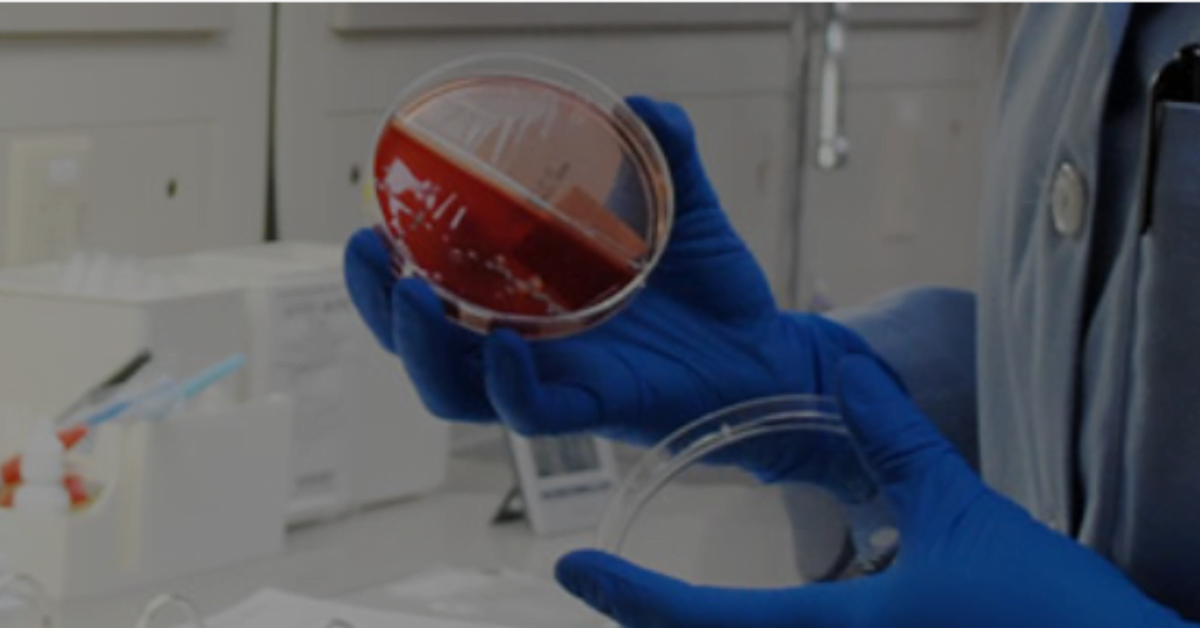
ICMR New Delhi Recruitment various posts

Indian Council of Medical Research, ICMR invites online applications for the following positions on Regular basis:
ICMR Hyderabad Recruitment various posts

Name of the Post
- Technical Assistant
- Technician-1
- Laboratory Attendant-1
Number of vacancies
- Technical Assistant – 45
- Technician 1 – 33
- Laboratory Attendant 1 – 38
Category classification
- UR-44
- SC-11
- ST-8
- OBC(NCL)-27
- EWS-26
- PwD-0
- Ex-SM-0
Pay Scale
- Technical Assistant – Rs.(35,400-1,12,400)/-
- Technician 1 – Rs.(19,900-63,200)/-
- Laboratory Attendant 1 – Rs.(18,000-56,900)/-

Essential qualification/Experience
ICMR Hyderabad Recruitment various posts
- Technical Assistant – Diploma/Bachelor’s Degree
- Technician 1 – 12th or Intermediate
- Laboratory Attendant 1 – 10th pass
Age Limit
- Technical Assistant – 30 years
- Technician 1 – 28 years
- Laboratory Attendant 1 – 25 years
Age relaxation
- SC/ST – 5 years
- OBC(NCL) – 3 years
- PWBD – 10 years
- PWD + OBC(NCL) – 13 years
- PWD + SC/ST – 15 years
- Ex-Servicemen – Period of Military service plus 03 years
- Ex-Servicemen(SC/ST) – 8 years
- Ex-Servicemen(OBC) – 5 years
Application Fee
- UR/OBC Candidates – Rs.1200/-
- SC/ST/PwD/EWS/Women – Rs.1000/-
Important Dates
- Date of opening of online application-17.07.2023
- Last date of submission of online application-14.08.2023